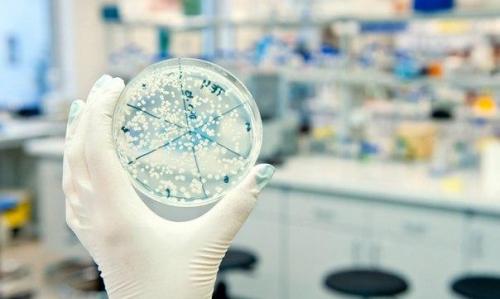
Ученые биокомпьютер из трех Видов микробов собрали. Ученые биокомпьютер из трех Видов микробов собрали.

Ученые биокомпьютер из трех Видов микробов собрали.
Международная группа биологов поставила перед собой задачу: вырастить простейший биокомпьютер, который будет управлять поведением других микробов. В перспективе это позволило бы запускать подобные биокомпьютеры в человеческий кишечник, где они будут инициировать производство лекарства, повышать активность микрофлоры или заниматься не менее полезными задачами.
Для создания простейшей логической схемы ученые три Вида микробов использовали. В два штамма кишечной палочки вставили два противоположных по смыслу набора генов.
Они заставляют микробы синтезировать сигнальные молекулы, которые включают или выключают определенный набор генов в третьем виде микробов.
Собрав все три компонента в одной емкости, ученые получили своеобразный аналог электронного "Маятника", который синхронизирует работу отдельных компонентов. Биологический "Маятник" в будущем можно использовать для управления работой более сложных биокомпьютеров в кишечнике.